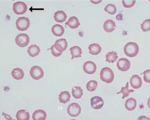

C-Reactive Protein (CRP, hs-CRP)
C-reactive protein (CRP) is a glycoprotein produced by the liver, which is normally absent from the blood. The presence of acute inflammation with tissue destruction within ...

Schilling Test (Vitamin B12 Absorption Test)
The Schilling test is used to evaluate the ability of the small intestine to absorb vitamin B12. When vitamin B12 is ingested, it combines with intrinsic factor from the gastric mucosa. ...

Low-Density Lipoprotein (LDL)
Cholesterol is synthesized in the liver from dietary fats. It is transported in the blood by the low density lipoproteins (LDLs, or “bad” cholesterol) and high density lipoproteins ...

Small vs Large lymphocytes
Small lymphocytes: These are the most common type in normal blood. They have a large, dense, round nucleus and thin basophilic cytoplasm and are capable of ameboid movement and the ...

Phenylketonuria Test
Phenylketonuria Test (PKU Test, Guthrie Test, Phenylalanine): Phenylalanine hydroxylase is an enzyme which converts phenylalanine to tyrosine.
A deficiency of this enzyme leads to ...

RBCs Agglutination
Agglutination is due to presence of antibodies reacting with antigens on RBCs.
It appear as irregular clumps of red cells. Found in auto immune haemolysis, blood transfusion reaction.

Prealbumin (PAB)
Prealbumin is a plasma protein synthesized by the liver. It is considered the best marker for malnutrition. It has a half-life of 2 days, so prealbumin levels change very quickly and ...

Antigliadin Antibodies [AGA]
Gliadin is part of the gluten protein found in wheat. Gliadin antibodies, also known as antigliadin antibodies (AGA) form in some individuals who are exposed to gluten over a period ...
Hypochromia
Hypochromia, used when central pallor exceeds one third of the cells diameter. Found in iron deficiency, thalassaemia, and any of the conditions leading to microcytosis.

Glucose Tolerance Test
The oral glucose tolerance test (OGTT) is performed to rule out diabetes by evaluating the rate at which glucose is removed from the blood stream. Following administration of an oral ...

Myoglobin
Myoglobin is a heme-containing, oxygen-binding protein which is present in the cytoplasm of cardiac and skeletal muscle cells. It serves as a reservoir of oxygen to meet very short-term ...

